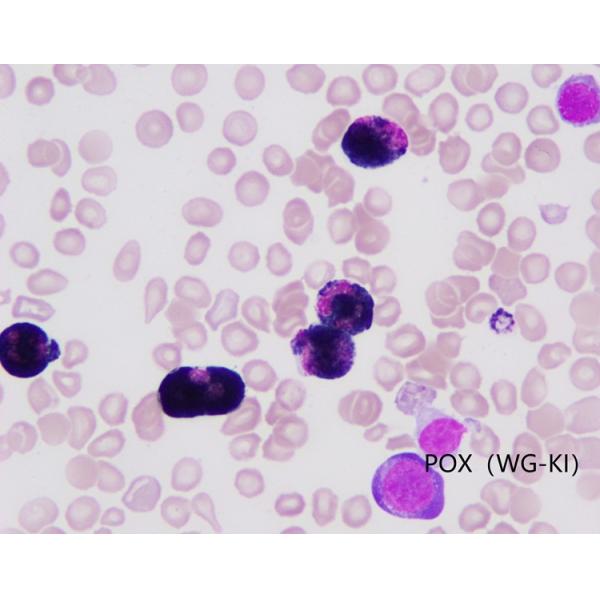
Método de oxidación de las manchas WG-KI

Maquinaria y equipo agrícola
(80080)
Vestuario y Maquinaria Textil
(75900)
Equipo de limpieza
(104054)
Equipos de energía y minerales
(127869)
Maquinaria Ambiental
(35590)
Robots industriales
(3603)
Equipos láser para la industria
(44115)
Equipo de máquina herramienta
(129643)
Accesorios para maquinaria
(202994)
Servicio de Maquinaria
(996)
Maquinaria de metal y metalurgia
(69132)
Maquina de empacado
(102444)
Lenguaje
English
Français
Русский язык
日本語
Português

Mostrar todas las categorías de máquinas
Maquinaria y equipo agrícola
(80080)
Vestuario y Maquinaria Textil
(75900)
Equipo de limpieza
(104054)
Equipos de energía y minerales
(127869)
Maquinaria Ambiental
(35590)
Robots industriales
(3603)
Equipos láser para la industria
(44115)
Equipo de máquina herramienta
(129643)
Accesorios para maquinaria
(202994)
Servicio de Maquinaria
(996)
Maquinaria de metal y metalurgia
(69132)
Maquina de empacado
(102444)